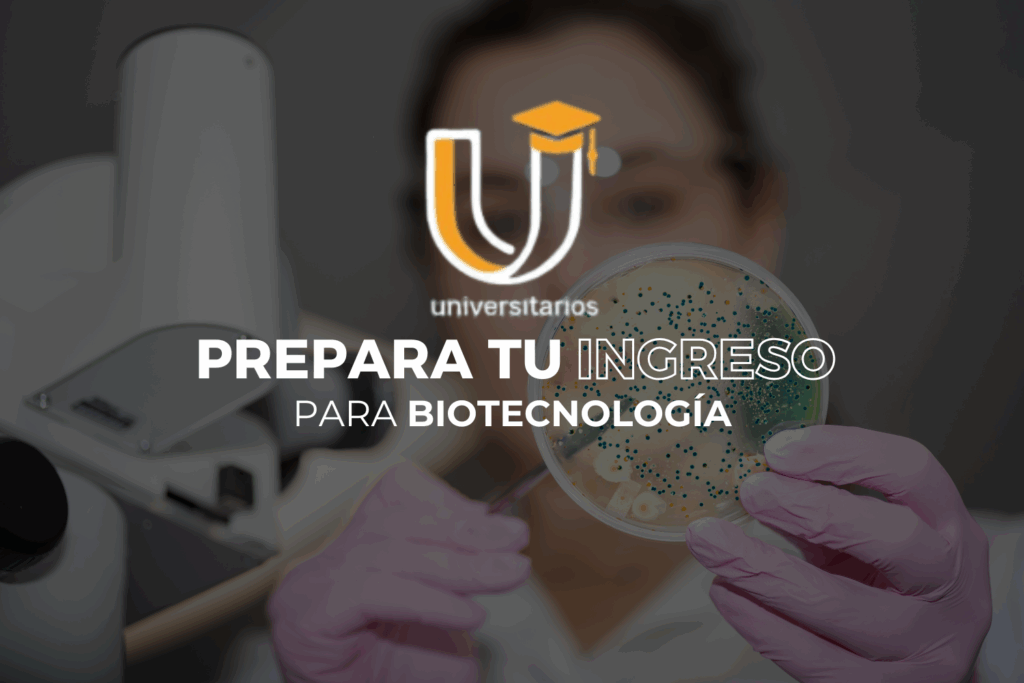

Prepará tu ingreso a Biotecnología con Fundación Cono Sur.
La carrera de Biotecnología combina ciencia, innovación y tecnología para dar respuesta a los grandes desafíos del futuro. Para ingresar con éxito necesitás una base sólida en biología, química, física y matemática, junto con habilidades de análisis y pensamiento crítico. En nuestra Preparatoria Universitaria te brindamos un acompañamiento integral que refuerza los contenidos esenciales y te prepara para afrontar con confianza el examen de ingreso. Con docentes especializados, materiales actualizados y estrategias de estudio efectivas, te ayudamos a desarrollar las competencias necesarias para comenzar tu recorrido en una disciplina clave para la salud, la producción y el desarrollo científico. En Fundación Cono Sur convertimos tu vocación en el punto de partida hacia una carrera con futuro.
¡Gracias por interesarte en nuestra Preparatoria 2026 para el Ingreso a Biotecnología!
Si tu meta es ingresar a la Universidad en 2027, esta es tu oportunidad.

Comienzo
Segunda mitad de Abril 2026

Duración
Desde Abril 2026 – Hasta Enero 2027
¿Qué te ofrecemos?

Clases en áreas claves
Matemática – Química.
Las clases se dan presenciales y por streaming. Se graban y se suben al aula virtual para que puedas verlas cuando quieras.

Aula Virtual
Material adicional, cuestionarios con preguntas de exámenes, simuladores virtuales, las clases grabadas, las presentaciones ppt, material pdf de la universidad, y muchos recursos más para facilitar tu aprendizaje.

Simulacros de examen
Resolvemos ejercicios similares a los del examen de ingreso a la Universidad y te damos devolución personalizada para mejorar tus conocimientos y aumentar tu confianza.

Material didáctico y simuladores
Maquetas, modelos y programas para comprender mejor las estructuras y funcionalidades.

Horarios de clases presenciales
Jueves 20 a 21Hs. – Química.
21 a 22hs – Matemáticas.

Si precisas otro plan de Pagos ¡¡Podemos adaptarnos!!

Sabemos lo importante que es tomar decisiones informadas, por eso te invitamos e invitamos a tus papás a acercarse si desean conversar personalmente para conocer más a fondo sobre nuestra propuesta. Avisanos y con gusto coordinamos un encuentro.
Si tienes preguntas, ¡no dudes en contactarnos!
Nos encantaría acompañarte en este camino hacia tu futuro en Biotecnología.
¡Te esperamos!

